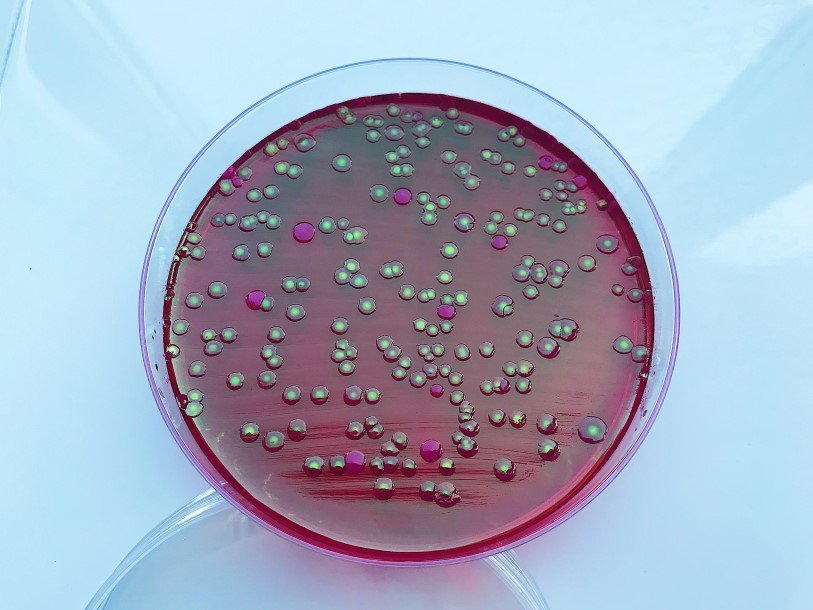

Екатерина Беленко: Промикробы: Двуликий Янус
Посмотрите на фотографию и попробуйте ответить — сколько видов микроорганизмов на этой чашке Петри? Большая часть колоний — блестящие, с золотистым отливом, но среди них заметны розово-малиновые. Думаю, вы ответили: «Два». Но это не так, на чашке растёт только кишечная палочка, просто она бывает разная.
⠀
Escherichia coli (E. coli) — это самая распиаренная бактерия, она обычно обнаруживается в нижних отделах кишечника теплокровных организмов. Ещё над ней ставят кучу генетических экспериментов, но сегодня не об этом. Число кишечных палочек Escherichia coli среди других представителей микрофлоры кишечника не превышает 1 %, но они играют важнейшую роль в функционировании желудочно-кишечного тракта. Кишечные палочки являются основными конкурентами условно-патогенной микрофлоры в отношении заселения ими кишечника. Трудяжки E.coli забирают из просвета кишечника кислород, который вреден для бифидо- и лактобактерий. А бифидо- и лактобактерии очень полезны нам с вами. Кроме того, кишечные палочки вырабатывают ряд необходимых для человека витаминов, да и вообще молодцы.
⠀
Но кишечная палочка имеет различия, связанные с ферментативной деятельностью. По существующим у нас стандартам, норма в кале безопасных для человека штаммов от 10 в 6-й степени до 10 в 8-й степени КОЕ/г. КОЕ – это одна колониеобразующая единица. Пользу для организма человека приносят лактозопозитивные штаммы. В норме в организме не должны присутствовать гемолитические разновидности, а лактозонегативных должно быть не более 10 в 5-й степени КОЕ/г.
⠀
Лактозонегативная кишечная палочка спокойно сосуществует с другими микроорганизмами в кишечнике человека, пока совокупность определённых благоприятных факторов для её роста не приведёт к повышенному её содержанию в организме. В этом случае кишечная палочка из условно-патогенной становится болезнетворной и вызывает различные заболевания. Чрезмерное размножение лактозонегативных штаммов может стать результатом антибиотикотерапии, когда антибактериальные препараты подавляют естественных антагонистов этой бактерии и тем самым создают для неё благоприятные условия.
⠀
Это далеко не все разновидности кишечных палочек. Ещё у бактериальных клеток есть разные антигены. Различают три типа антигенов эшерихий: О-антиген (соматический), К-антиген (капсульный) и Н-антиген (жгутиковый). Но это уже совсем сложно, даже для меня. А у этого пациента всё в границах нормы — добрых кишечных палочек много, а потенциальных предателей мало. Чего и вам желаю, мои дорогие.